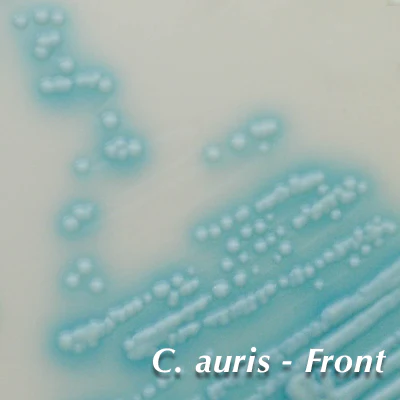
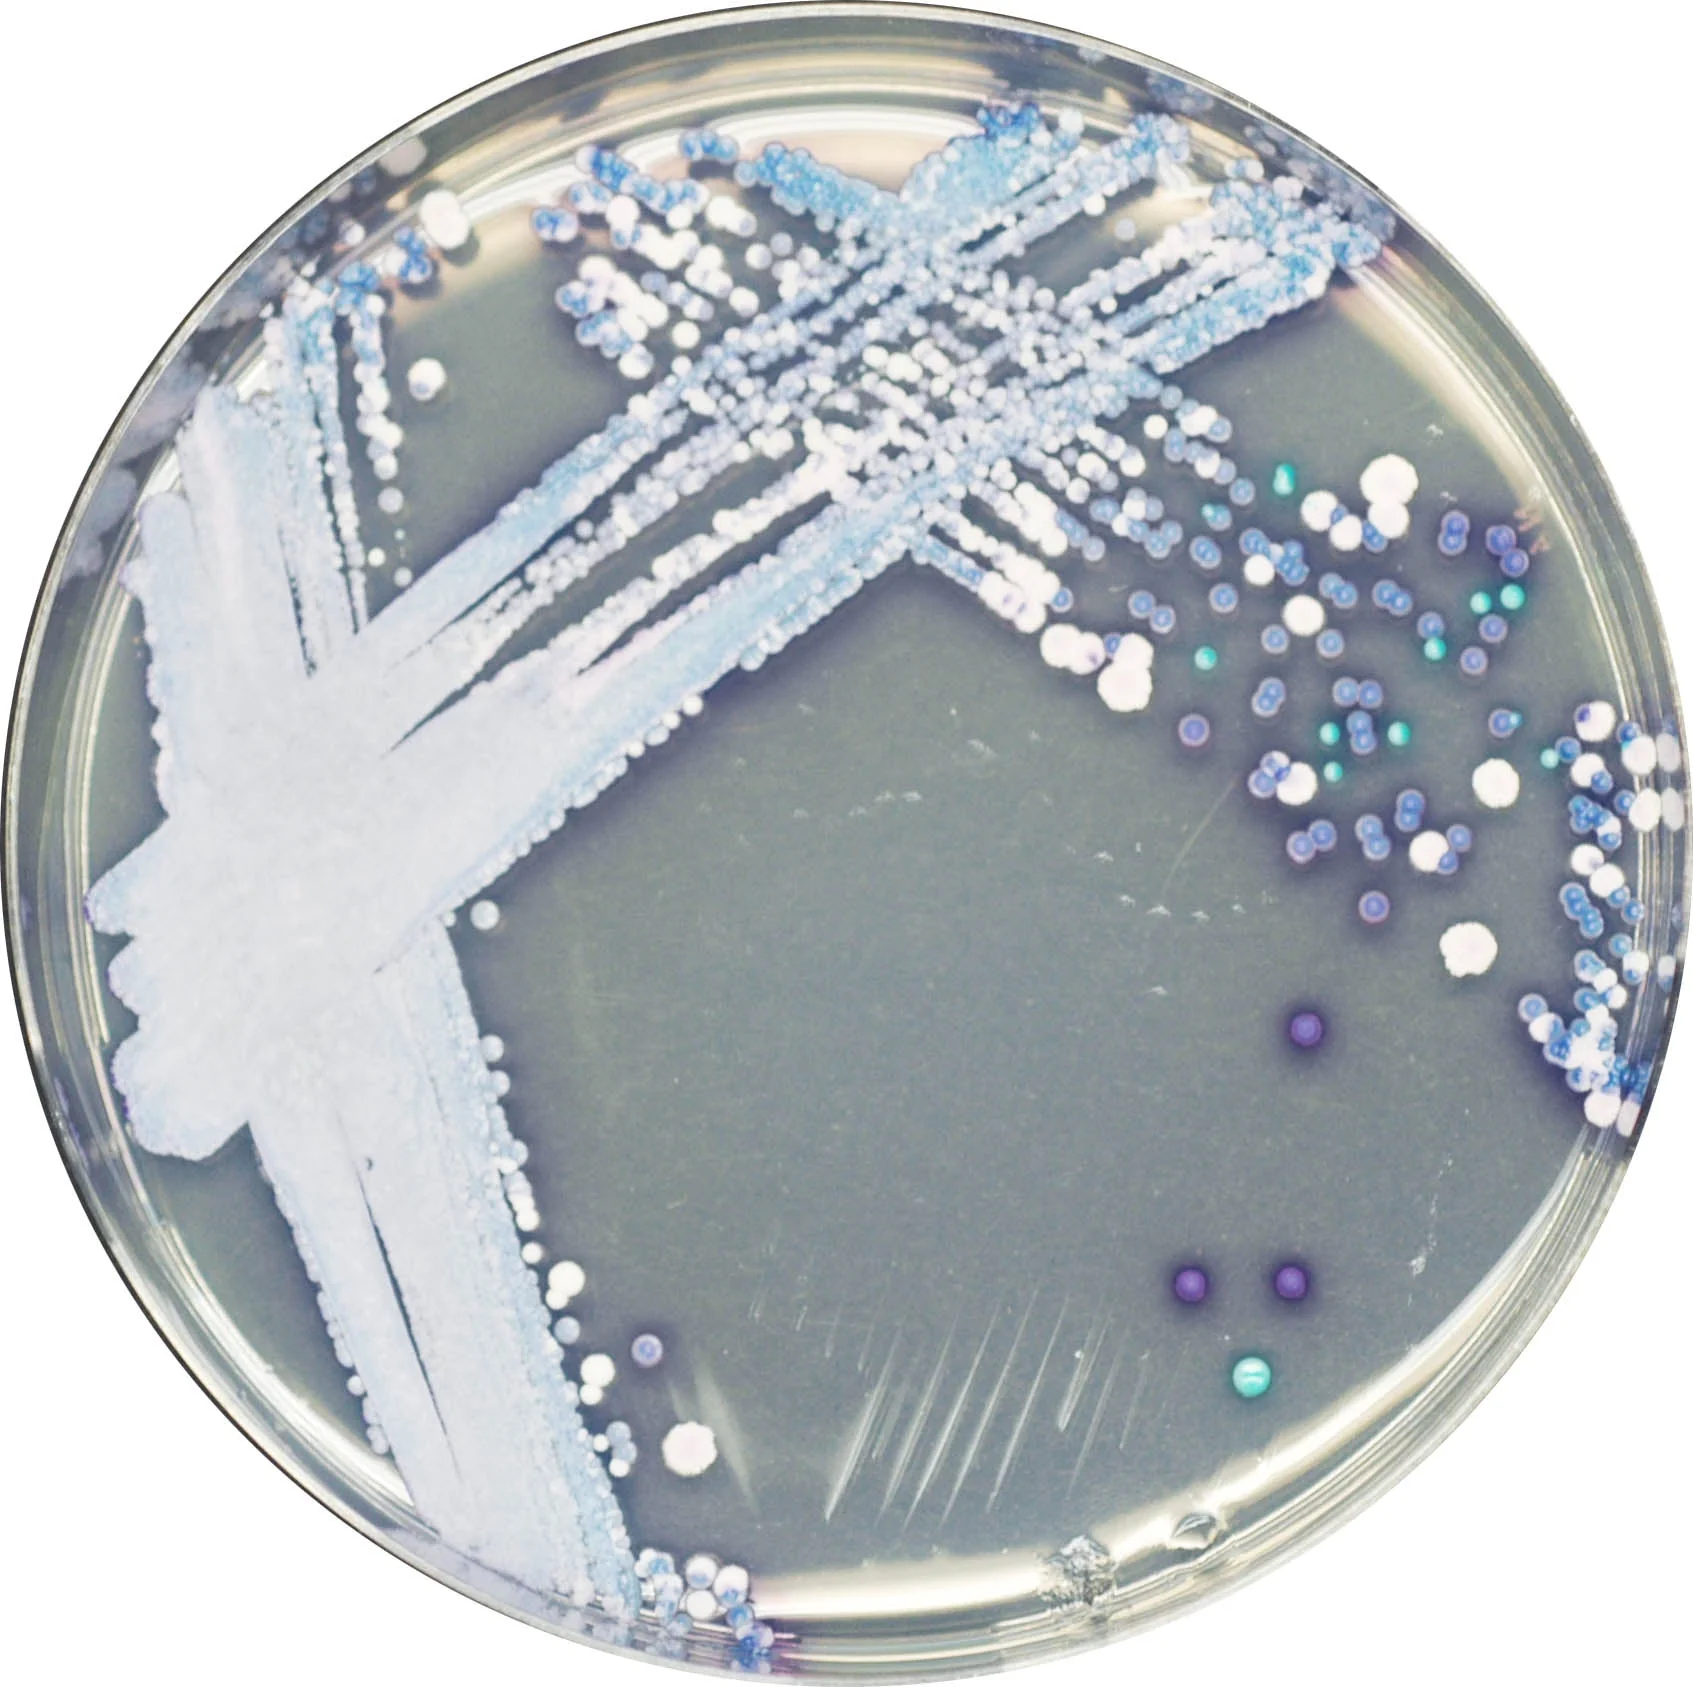
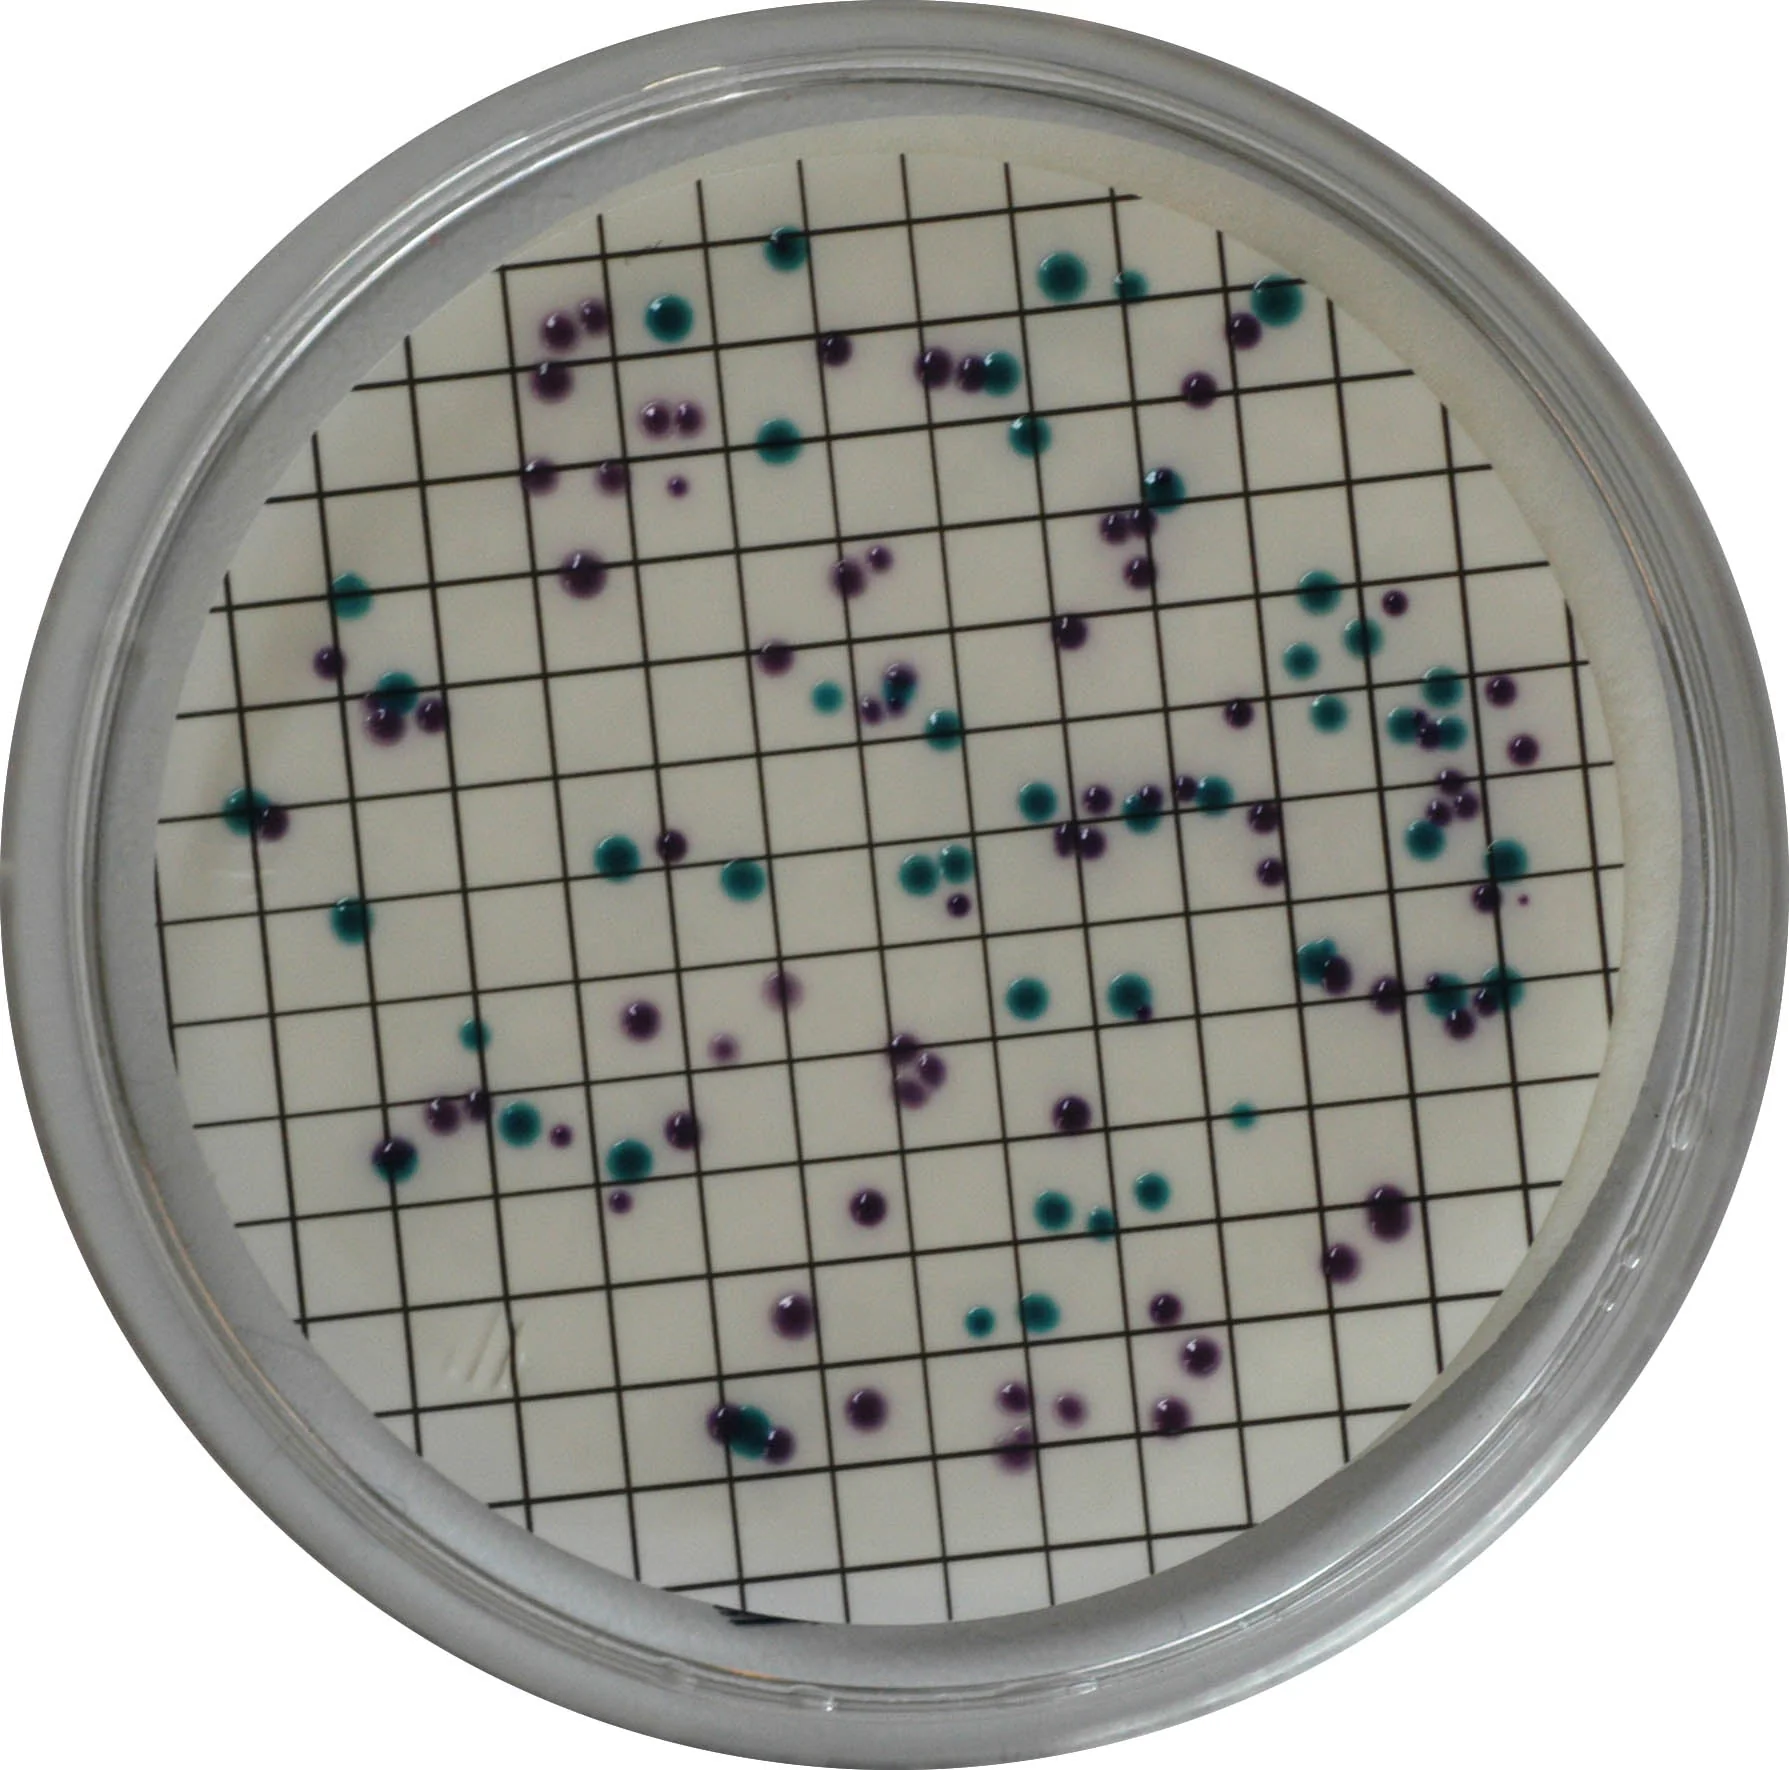
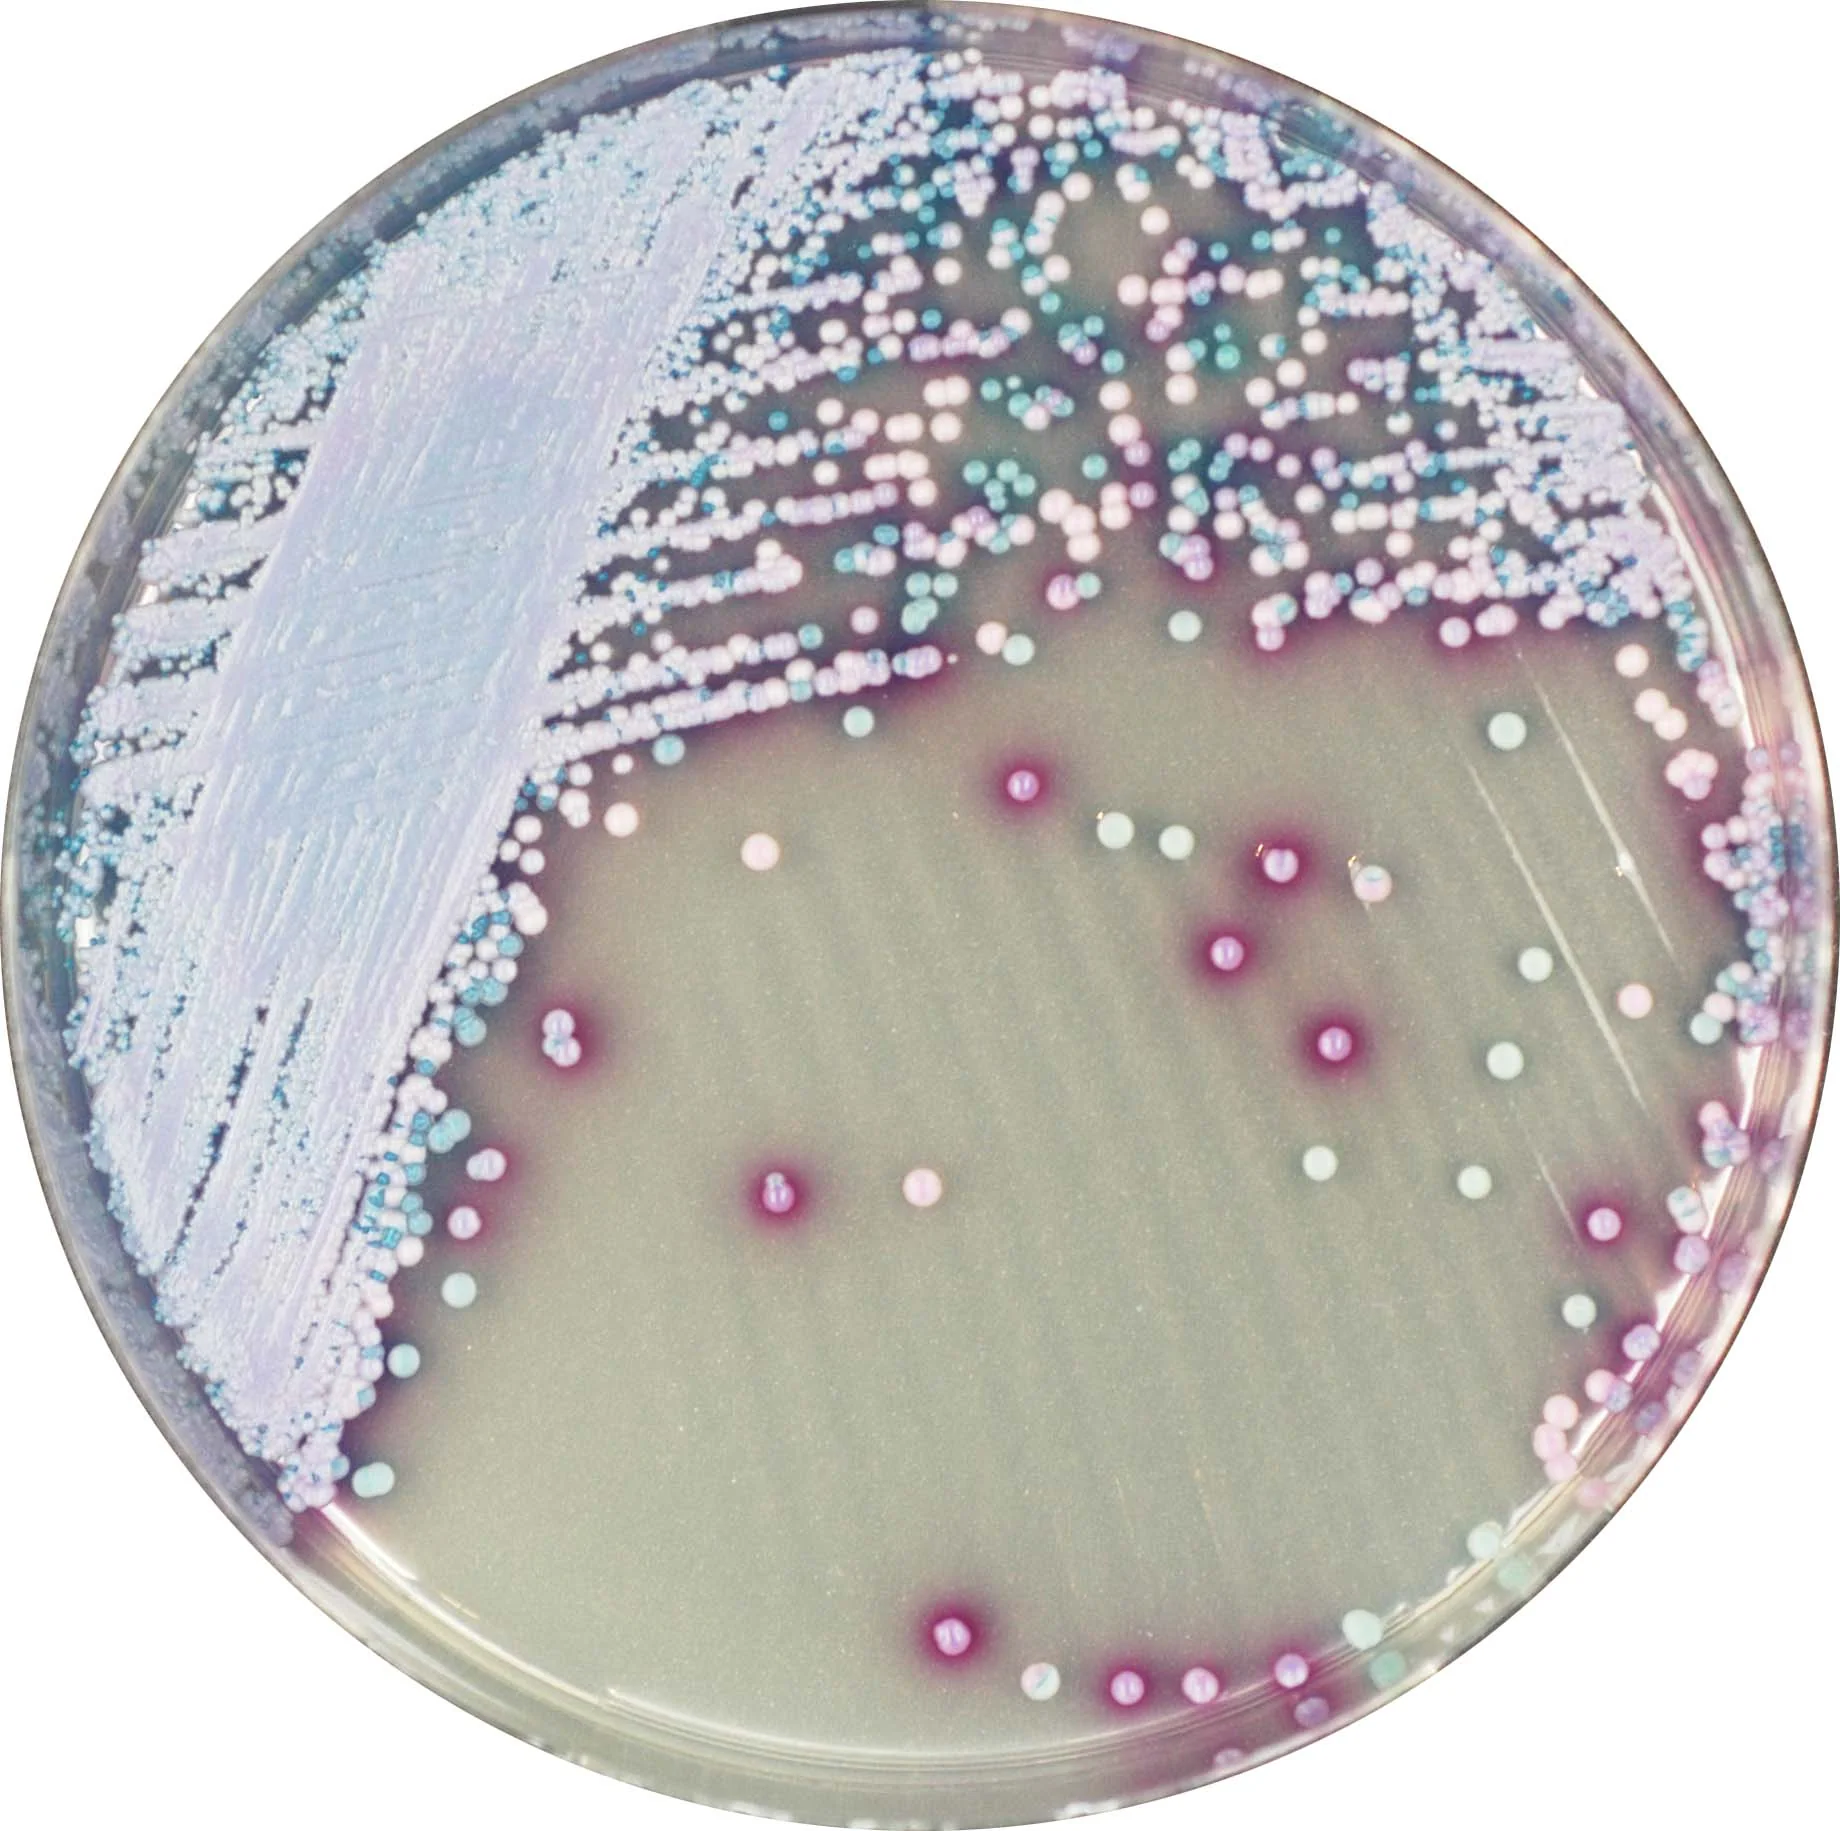

Bactériologie
Bactériologie
Bienvenue sur notre page dédiée à la Bactériologie Médicale chez DSA. Nous vous invitons à explorer le monde fascinant des micro-organismes, guidés par notre engagement envers l’excellence scientifique et notre réputation dans la distribution médicale.
Exploration Microbiologique:
Plongez avec DSA dans les avancées récentes en Bactériologie Médicale. Notre équipe d’experts décode les mystères microbiologiques, fournissant des informations cruciales pour la communauté médicale. Chaque découverte contribue à élargir notre compréhension des micro-organismes et à améliorer les solutions médicales que nous offrons.
Solutions Médicales Innovantes:
Chez DSA, notre engagement va au-delà de l’exploration. Nous innovons également dans le domaine des solutions médicales. Explorez notre gamme de produits conçus pour relever les défis posés par les micro-organismes. Nous sommes fiers de contribuer activement à l’avancement de la médecine grâce à nos solutions novatrices.
Engagement envers la Santé Publique:
L’engagement de DSA envers la santé publique est évident dans chaque aspect de notre travail en Bactériologie Médicale. Nous nous engageons à fournir des informations précieuses, des solutions de qualité et à contribuer à l’amélioration constante des pratiques médicales dans le domaine de la microbiologie.
Rejoignez-nous dans cette exploration fascinante de la Bactériologie Médicale avec DSA. Nous sommes votre partenaire dévoué dans la découverte et l’innovation, façonnant un avenir plus sain grâce à une compréhension approfondie des micro-organismes. #Bactériologie #Microbiologie #InnovationMédicale #DSA